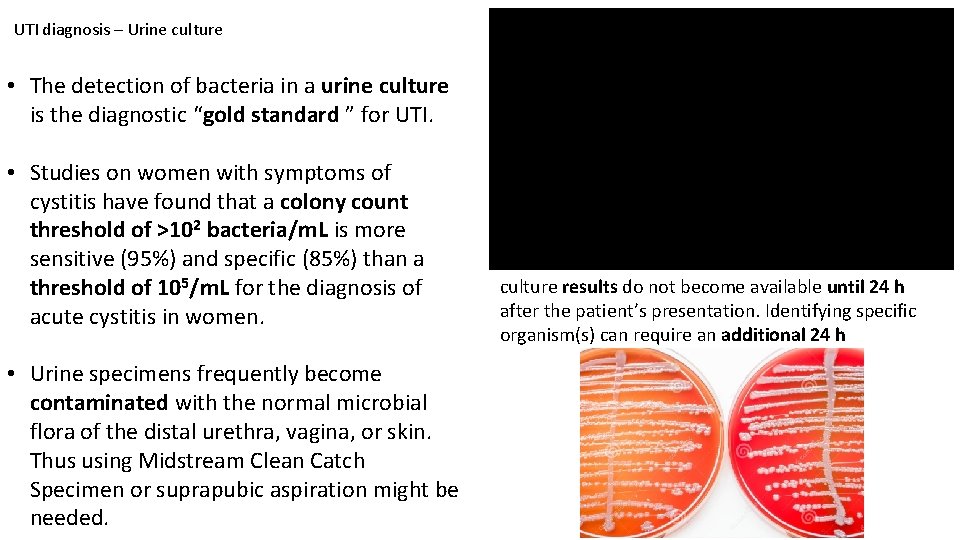
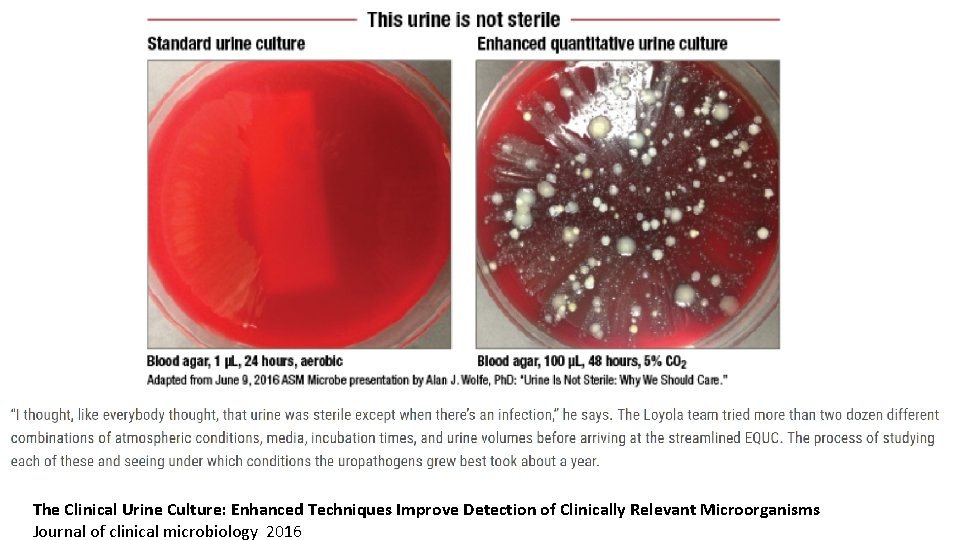

Microbiology of Urogenital system Anas AbuHumaidan M D

Microbiology of Urogenital system Anas Abu-Humaidan M. D. Ph. D. Lecture 2

How do UTI patients present? The term urinary tract infection (UTI) encompasses a variety of clinical entities, including : • • Asymptomatic bacteriuria (ASB) Cystitis Pyelonephritis. Prostatitis

Cystitis and pyelonephritis • The typical symptoms of cystitis are dysuria, urinary frequency, and urgency. Nocturia, hesitancy, suprapubic discomfort, and gross hematuria are often note as well. • Mild pyelonephritis can present as low-grade fever with or without lower-back or costovertebral-angle pain. • Severe pyelonephritis can manifest as high fever, rigors, nausea, vomiting, an flank and /or loin pain. • Constitutional symptoms, such as fever, are mild or absent in cystitis, but commonly found in pyelonephritis. Murphy’s percussion test is also known as costovertebral angle tenderness

Cystitis and pyelonephritis Clinical Features and Virulence Mechanisms in Cystitis and Pyelonephritis

UTI diagnosis – History and self diagnosis • The diagnosis of any of the UTI syndromes or ASB begins with a detailed history. (E. g. in women presenting with at least one symptom of UTI ( dysuria, frequency, hematuria, or back pain) and without complicating factors, the probability of acute cystitis or pyelonephritis is 50% ). • If vaginal discharge and complicating factors are absent and risk factors for UTI are present, then the probability of UTI is close to 90%, and no laboratory evaluation is needed before initiation of therapy. • One significant concern is that sexually transmitted disease—that caused by Chlamydia trachomatis in particular—may be inappropriately treated as UTI.

UTI diagnosis – dipstick and urinalysis • dipstick and urinalysis provide point-of -care information Some points to consider: • Only members of the family Enterobacteriaceae convert nitrate to nitrite. • When voiding frequently, the dipstick test or nitrite is less likely to be positive. • The leukocyte esterase test detects this enzyme in the host’s polymorphonuclear leukocytes in the urine. • A negative dipstick test is not sufficiently sensitive to rule out bacteriuria in pregnant women, in whom it is important to detect all episodes of bacteriuria.
UTI diagnosis – Urine culture • The detection of bacteria in a urine culture is the diagnostic “gold standard ” for UTI. • Studies on women with symptoms of cystitis have found that a colony count threshold of >102 bacteria/m. L is more sensitive (95%) and specific (85%) than a threshold of 105/m. L for the diagnosis of acute cystitis in women. • Urine specimens frequently become contaminated with the normal microbial flora of the distal urethra, vagina, or skin. Thus using Midstream Clean Catch Specimen or suprapubic aspiration might be needed. culture results do not become available until 24 h after the patient’s presentation. Identifying specific organism(s) can require an additional 24 h

UTI treatment • Antimicrobial therapy is warranted for any symptomatic UTI. • The choice of antimicrobial agent and the onset and duration of therapy depend on the site of infection and the presence or absence of complicating conditions. • Antimicrobial resistance among uropathogens varies from region to region and impacts the approach to empirical treatment of UTI.

UTI treatment • Antimicrobial therapy is warranted for any symptomatic UTI. • The choice of antimicrobial agent and the onset and duration of therapy depend on the site of infection and the presence or absence of complicating conditions. • Antimicrobial resistance among uropathogens varies from region to region and impacts the approach to empirical treatment of UTI.

The result of different examination test suggest that the Escherichia coli is responsible for the large proportion of infection (53. 24%), followed by other strains like Enterococcus faecalis (24. 05%), Proteus sp. (19. 537%), Staphylococcus aureus (19. 206%), Staphylococcus epidermidis (7. 8%), Staphylococcus saprophyticus (13. 2%), Klebsiella sp. (11. 96%), Enterobacter sp. (5. 128%), Pseudomonas aeruginosa (3. 4%), Citrobacter sp. 1. 92% and Serratia marcescens (0. 8%). For the treatment of urinary tract infection the antibiotic Ciprofloxacin (5 μg disk-1) was found to be most effective antimicrobial agents against all isolated bacteria strains, while Oxacillin (1 μg disk-1) was found to be the least effective.

Complications of pyelonephritis • A single episode of acute pyelonephritis in an adult woman can lead to renal scarring. • Pyelonephritis becomes potentially fatal when secondary conditions develop such as emphysematous pyelonephritis (20– 80% mortality rate), perinephric abscess (20– 50% mortality rate), or sepsis. • Chronic pyelonephritis might develop following acute pyelonephritis in childhood in the context of (vesicoureteric reflux) VUR.

Complications of pyelonephritis • Emphysematous pyelonephritis: A severe, necrotizing, acute, multifocal bacterial nephritis, with extension of the infection through the renal capsule. Gas is found in the renal substance and perinephric space. Often happens in diabetics. • Diagnosis is confirmed by CT scan. • Treatment involves antibiotics, drainage, nephrectomy. • Mortality is high (around 60%)

Complications of pyelonephritis • Xanthogranulomatous pyelonephritis, A rare, serious, debilitating illness characterized by a chronic inflammatory mass originating in the renal parenchyma. • Gross appearance: mass of yellow tissue composed of lipid- laden macrophages and inflammatory cells regional necrosis, and haemorrhage. • Often associated with infection by Proteus, E. coli, or Pseudomonas spp. in the context of chronic obstruction. A large staghorn calculus (arrow) is seen obstructing the renal pelvis and calyceal system. The lower pole of the kidney shows areas of hemorrhage and necrosis with collapse o cortical areas.

Prostatitis • Up to 50% of men will experience symptoms of prostatitis at some time in their lives. • Prostatitis includes both infectious an non-infectious abnormalities of the prostate gland. • Acute bacterial prostatitis presents as dysuria, frequency, and pain in the prostatic pelvic or perineal area. Fever and chills are usually present, an symptoms of bladder outlet obstruction are common. • Chronic/ recurrent bacterial prostatitis occurs in young and middle- aged men. Risk factors include previous acute prostatitis, history of prior manipulation of the urinary tract, diabetes, smoking.

Further reading: • Oxford handbook of infectious diseases and microbiology. Part 4: Clinical syndroms Chapter 17 Urinary tract infections • Harrison's Infectious Diseases 3 rd Edition SECTION III Infections in organ systems Chapter 33
The Clinical Urine Culture: Enhanced Techniques Improve Detection of Clinically Relevant Microorganisms Journal of clinical microbiology 2016
- Slides: 16